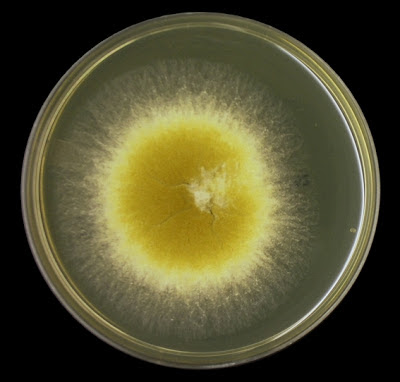

Arthrographis species (Mould)
Ecology: Arthrographisis widespread, found in compost, decaying plant material and in the soil.
Pathology: Arthrographisis generally considered to be a contaminant. Arthrographis kalrae has possibly been implicated in eye and central nervous system infections as well as onychomycosis (nail infections). A case of ethmoid sinusitis has also been reported. Arthrographis cuboidea* has been isolated from bronchial wash specimens however its pathogenicity remains unsubstantiated. Other recognized species are A.lignicola, A.pinicola, A.sulphurea and A.alba however they have yet to be implicated as human pathogens.
*Recent molecular study appears to have reclassified this fungus, now known as Scytalidium cuboideum. I will use the previous name throughout this post as I have found but a few references to this change.
Physiology: Arthrographis cuboidea exhibits relatively fast growth at 25 – 30oC, maturing in about 3 to 5 days. It grows equally well at 37oC at which temperature it may develop a pink to lavender pigment on prolonged incubation, however it fails to grow at 45oC A.cuboidea possesses strong cellulolytic activity which can cause a pink coloured ‘spalting’ in many species of hardwoods.
Arthrographis kalrae exhibits slow growth between 25 - 30oC, maturing within 1 to 3 weeks. Growth may be enhanced at 37oC, perhaps giving it some advantage as a human pathogen. A.kalraeis capable of growing at 45oC which helps to distinguish it from A.cuboidea. A.kalrae is resistant to cycloheximide.
Macroscopic Morphology: (Species dependant)
A.cuboidea– rather fast growing as discussed above. Colonies are generally described as cottony to granular. Radial ridges or folds may develop. Colouration is white to pale yellow with a yellow reverse. A pink to lavender pigment may develop and diffuse into the media on prolonged incubation.
A.kalrae– is initially glabrous, smooth and yeast-like. Colonies are slightly raised and become velvety or powdery as they develop. Colour is described as a pale yellow (cream) to yellow-buff to tan. The reverse is pale yellow to tan in colour.
Arthrographis species - SAB, 72 hrs at 30oC
Arthrographis species - Note no noticeable pink or lavender pigment on prolonged incubation.
Microscopic Morphology: Both species produce hyaline, septate hyphae. Arthrographis species develop conidiophores which differentiates this species fromGeotrichum& Scytalidium[i]. Conidiophores are generally short and can be branched or unbranched. The arthroconidia which are produced from the conidiophores are smooth single celled and hyaline. Arthroconidia produced from the conidiophores are rectangular to cylindrical in shape and are usually produced in chains. With A.cuboidea, arthroconidia formed from undifferentiated hyphae are generally square or rectangular in shape. A. kalrae may also produce lateral sessile (blastoconidia/aleuroconidia) which may be submerged in the agar and difficult to discern. Intercalary arthroconidia may arise from undifferentiated hyphae and are generally longer and narrower than those produced from the conidiophores. Arthroconidia separate by fission through double septa.Note: All photos which appear below were taken with the DMD-108 digital microscope.
Arthrographis species - hyphae bearing conidiophores from which chains of arthroconidia extend.
(LPCB, X400)
Arthrographis species - as above but a closer look. The larger or somewhat 'swollen' structures (arrows), point to the conidiophores. Chains of arthroconidia are seen extending from the conidiophores. (LPCB, X400+10, DMD-108)
Arthrographis species - another look at the septate hyphae, conidiophors and chains of conidia. Note the 100 µm bar in upper right for scale.
(LPCB, X400)
Arthrographis species - Branched hyphae with conidiophores and chains of arthroconidia
(LPCB, X400+10)
Arthrographis species - intercalary conidophores, Chains of arthroconidia have collapsed around the tip. No, this is not a mixed culture. (LPCB, X400)
Arthrographis species - long chain of cylindrical or barrel shaped arthroconidia. Smaller, narrower conidia (intercalary?) seen bunched may be those produced from an undifferentiated hyphae discussed above. (LPCB, X 400+10)
Arthrographis species - Conidiophores bearing arthroconidia extending from hyphae.
(LPCB, 1000+10)
Arthrographis species - as above
(LPCB, X1000)
Arthrographis species - Again, an older culture - branched conidiophores extend from a hyphae with arthrospores collapsed around tip.
(LPCB, X1000)
Arthrographis species - longer, narrower intercalary conidia extending from undifferentiated hyphae.
(LPCB, X1000)
Arthrographis species - as above (LPCB, X1000+10)
Arthrographis species - one feature I haven't found mentioned in any of my resource material is the small lateral structure at the tip of the conidiophore. Any ideas?
(LPCB, X1000)
Arthrographis species - the curious structure found at the tip of the conidiophore.
(LPCB, X1000)
Arthrographis species - One last view of the curious lateral structure found at the tip of the conidophores of this particular species. I have not found mention of this structure in any of my resource material. (LPCB, X1000+10)
(LPCB, X400)
Arthrographis species - as above but a closer look. The larger or somewhat 'swollen' structures (arrows), point to the conidiophores. Chains of arthroconidia are seen extending from the conidiophores. (LPCB, X400+10, DMD-108)
Arthrographis species - another look at the septate hyphae, conidiophors and chains of conidia. Note the 100 µm bar in upper right for scale.
(LPCB, X400)
Arthrographis species - Branched hyphae with conidiophores and chains of arthroconidia
(LPCB, X400+10)
Arthrographis species - intercalary conidophores, Chains of arthroconidia have collapsed around the tip. No, this is not a mixed culture. (LPCB, X400)
Arthrographis species - long chain of cylindrical or barrel shaped arthroconidia. Smaller, narrower conidia (intercalary?) seen bunched may be those produced from an undifferentiated hyphae discussed above. (LPCB, X 400+10)
Arthrographis species - Conidiophores bearing arthroconidia extending from hyphae.
(LPCB, 1000+10)
Arthrographis species - the two types of conidia as discussed above are shown in this photo.
(LPCB X400)
Arthrographis species - An older culture. Septate hyphae with conidiophores bearing chains of arthroconidia. (LPCB, X1000)
(LPCB, X1000)
Arthrographis species - Again, an older culture - branched conidiophores extend from a hyphae with arthrospores collapsed around tip.
(LPCB, X1000)
Arthrographis species - longer, narrower intercalary conidia extending from undifferentiated hyphae.
(LPCB, X1000)
Arthrographis species - as above (LPCB, X1000+10)
Arthrographis species - one feature I haven't found mentioned in any of my resource material is the small lateral structure at the tip of the conidiophore. Any ideas?
(LPCB, X1000)
Arthrographis species - the curious structure found at the tip of the conidiophore.
(LPCB, X1000)
Arthrographis species - One last view of the curious lateral structure found at the tip of the conidophores of this particular species. I have not found mention of this structure in any of my resource material. (LPCB, X1000+10)
Note: I won’t venture a guess at what specific species I’ve isolated here. Growth was quite rapid and produced a pale yellow pigment favouring C.cuboidea. I did not attempt temperature studies. While the species survived on Dermasil™ media containing cycloheximide, growth was weak and stunted. Only molecular studies would provide the definitive identification.
[i] Recent molecular study appears to have reclassified this fungus, now known as Scytalidium cuboideum. I have not found reference to this reclassification nor how the presence or absence of conidiophores is reconciled.